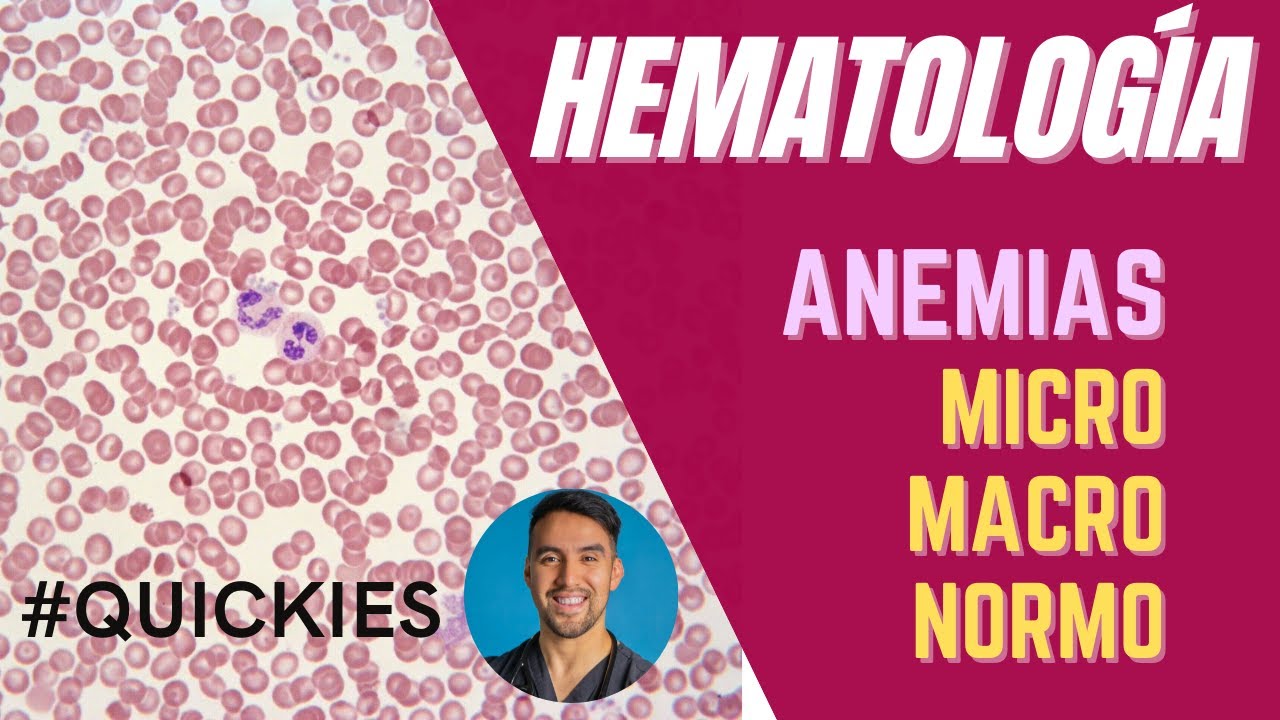
ANEMIAS normocíticas, macrocíticas y microcítica.- un resumen práctico

¡INTERPRETA ARTÍCULOS CIENTÍFICOS FT. SANTIAGO ESPINOSA | FITELIGENTE! скачать в хорошем качестве
Повторяем попытку...

Скачать видео с ютуб по ссылке или смотреть без блокировок на сайте: ¡INTERPRETA ARTÍCULOS CIENTÍFICOS FT. SANTIAGO ESPINOSA | FITELIGENTE! в качестве 4k
У нас вы можете посмотреть бесплатно ¡INTERPRETA ARTÍCULOS CIENTÍFICOS FT. SANTIAGO ESPINOSA | FITELIGENTE! или скачать в максимальном доступном качестве, видео которое было загружено на ютуб. Для загрузки выберите вариант из формы ниже:
-
Информация по загрузке:
Скачать mp3 с ютуба отдельным файлом. Бесплатный рингтон ¡INTERPRETA ARTÍCULOS CIENTÍFICOS FT. SANTIAGO ESPINOSA | FITELIGENTE! в формате MP3:
Если кнопки скачивания не
загрузились
НАЖМИТЕ ЗДЕСЬ или обновите страницу
Если возникают проблемы со скачиванием видео, пожалуйста напишите в поддержку по адресу внизу
страницы.
Спасибо за использование сервиса ClipSaver.ru
¡INTERPRETA ARTÍCULOS CIENTÍFICOS FT. SANTIAGO ESPINOSA | FITELIGENTE!
****ABRE ESTA CAJITA***** Subscríbanse al Canal de FITELIGENTE: / @fiteligente ¡Amigos! Ojalá se encuentren muy bien y cuidándose mucho esta cuarentena en este video de 20 minutos estamos celebrando que ya somos 7000+ Suscriptores!! No tengo nada más que agradecerles a cada uno de ustedes que han apoyado este que es su canal. Y como motivo de celebración, tuvimos un invitado súper especial, Santiago Espinosa de FITELIGENTE! En este video tocaremos los 5 puntos más importantes respecto a la interpretación apropiada de artículos científicos. ¡Acompáñanos a Santiago y a mí en este video, que sin duda estoy seguro que será uno de sus favoritos! ¡Aquí para seguirnos en instagram! Santiago Espinosa: / fiteligente Pavel Pichardo: / pavel.pichardo.md / mednotes.pp Quieres programar una asesoría para ti? contáctame en fb: / asesor%c3%ada-acad%c3%a9mica-pavel-pichard... ¡Únete a los +7000 estudiantes que me han dado la oportunidad de ayudarlos con diagramas, explicaciones y videos fáciles de digerir! La información proviene de sitios confiables, como artículos, libros de texto y recomendaciones de grandes médicos que ayudaron en mi formación de Estados Unidos y México. Mi meta es tratar de promover educación médica y de ciencias de la salud de calidad así como gratuita para la formación mexicana y ayudar a la formación de grandes enfermeros, médicos, psicólogos, nutriólogos, dentistas y áreas relacionadas con la salud. Programa de dibujo: SketchBook Disclaimer: No soy dueño de las imágenes que uso de referencia , siempre son citadas y se usan solo con fines educativos . Solo me considero autor creativo de los diagramas productos de estos. Las recomendaciones que menciono son meramente con fines explicativos y no constituyen bases diagnósticas o terapéuticas, las enfermedades siempre deben de tratarse con un personal médico de salud capacitado.